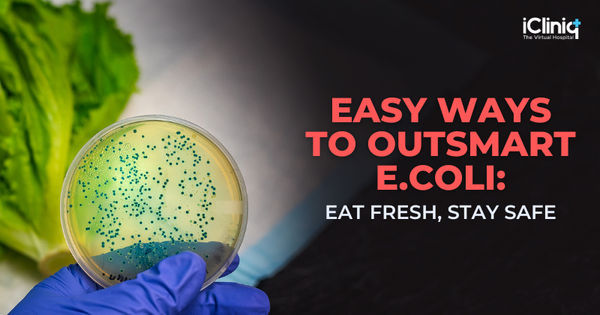
Easy Ways to Outsmart E. coli: Eat Fresh, Stay Safe

Health and Lifestyle
Easy Ways to Outsmart E. coli: Eat Fresh, Stay Safe
E. coli infections can occur anytime, anywhere, to anyone, Yes, this infection can strike when least expected. The main culprit? Contaminated food or water that most people do not know is contaminated. But not all the E. coli strains make people sick, some are beneficial to the human gut and
